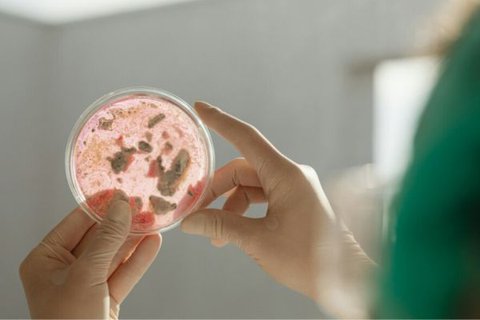

Υγεία
Πετάξτε από την κουζίνα τα μαύρα πλαστικά μαγειρικά σκεύη
Μελέτη δείχνει ότι είναι επικίνδυνα για την υγεία μας.


Η συζήτηση για τα μαύρα πλαστικά μαγειρικά σκεύη στις κουζίνες μας και το πόσο ασφαλή είναι αυτά έχει ξεκινήσει εδώ και λίγο διάστημα που έχουν γίνει «trend».
Αυτή η μαύρη πλαστική σπάτουλα στο συρτάρι της κουζίνας μας μπορεί να είναι πολύ στιλάτη για το μοντέρνο μας σπίτι, όμως είναι όσο ασφαλής πρέπει να την υγεία μας;
Οι κίνδυνοι μαγειρέματος με μαύρα πλαστικά σκεύη - όπως τα κουτάλια, οι σπάτουλες και πολλά άλλα - έχει να κάνει με τον απλό ισχυρισμό πως η χρήση μαύρου πλαστικού στις κατσαρόλες και τα τηγάνια σας, σε πολύ υψηλές θερμοκρασίες, δηλαδή, μπορεί να απελευθερώσει χημικές ουσίες στο φαγητό. Μια μελέτη μάλιστα υποδηλώνει ότι το κύριο πρόβλημα είναι η χρήση ανακυκλωμένων πλαστικών σε αυτά τα μαγειρικά σκεύη, καθώς μέσω της ανακύκλωσης, ενδέχεται να περιλαμβάνονται στα μαύρα πλαστικά χημικές ουσίες που μπορεί να γίνουν τοξικές όταν εκτεθούν στη θερμότητα.
Είναι πραγματικά κακό να μαγειρεύεις με μαύρα πλαστικά σκεύη;
Αν και πολλοί έσπευσαν να καταδικάσουν το μαγείρεμα με μαύρο πλαστικό, ειδικοί που μίλησαν στο αμερικανικό δίκτυο NBC υποστηρίζουν ότι δεν είναι τόσο ξεκάθαρο και ότι εξαρτάται από τον τύπο του πλαστικού που χρησιμοποιείται για τη δημιουργία αυτών των σκευών.
«Γενικά, τα πλαστικά μαγειρικά σκεύη, όπως αυτά που κατασκευάζονται από πολυπροπυλένιο ή γνωστά ως PP, θεωρούνται ασφαλή επειδή είναι ανθεκτικά και μπορούν να ανταπεξέλθουν σε υψηλή θερμότητα», λέει ο Δρ Λι Λι, επίκουρος καθηγητής στο Πανεπιστήμιο της Νεβάδα που ειδικεύεται στην περιβαλλοντική χημεία, τη βιομηχανική οικολογία και τις επιστήμες υγείας. «Ωστόσο, ορισμένα πλαστικά σκεύη μπορεί να είναι κατασκευασμένα από ανακυκλωμένα πλαστικά και μερικά από αυτά τα πλαστικά μπορεί να προέρχονται από προϊόντα που δεν προορίζονται αρχικά για χρήση σε τρόφιμα».
Είναι, επομένως, το ανακυκλωμένο πλαστικό που μπορεί να προκαλέσει προβλήματα. Αυτό συμβαίνει επειδή μπορεί να περιέχει επιβλαβή πρόσθετα που δεν προορίζονται για χρήση σε τρόφιμα. «Ένα παράδειγμα αυτού είναι τα επιβραδυντικά φλόγας, όπως οι πολυβρωμιωμένοι διφαινυλαιθέρες (PBDEs)», λέει ο Δρ Λι. «Αυτές οι χημικές ουσίες προστίθενται σε πλαστικά που δεν έρχονται σε επαφή με τρόφιμα για να αποτρέπουν την ανάφλεξη σε υψηλές θερμοκρασίες. Αλλά δεν μπορούν να καταστραφούν κατά τη διαδικασία ανακύκλωσης και έτσι θα εμφανιστούν εάν αυτό το ανακυκλωμένο υλικό μετατραπεί σε μαγειρικό σκεύος».
Αυτά τα PBDE έχουν συνδεθεί με διάφορες ανησυχίες για την υγεία. «Όταν θερμαίνονται, αυτές οι χημικές ουσίες μπορούν να μετακινηθούν στα τρόφιμα, δυνητικά διαταράσσοντας τις ορμόνες και θέτοντας μακροπρόθεσμους κινδύνους για την υγεία, όπως ενδοκρινικές διαταραχές ή αυξημένο κίνδυνο καρκίνου», λέει η Δρ Σούζαν Χάρλαντερ, η οποία έχει το διδακτορικό της στην επιστήμη των τροφίμων και τη διατροφή και είναι η αντιπρόεδρος τεχνολογίας στη Ra Foods.
Όχι μόνο υπάρχουν ανησυχίες για την υγεία, αλλά η Χάρλαντερ λέει ότι το μαύρο πλαστικό μπορεί να δημιουργήσει κυρίως, περιβαλλοντικά προβλήματα. «Συχνά δεν είναι ανακυκλώσιμο λόγω δυσκολιών στη διαλογή του με συστήματα υπερύθρων στις εγκαταστάσεις ανακύκλωσης, με αποτέλεσμα υψηλότερα απόβλητα στις χωματερές», λέει. «Επιπλέον, κατά την κατασκευή και την απόρριψη, το μαύρο πλαστικό μπορεί να απελευθερώσει επίμονους οργανικούς ρύπους, οι οποίοι βλάπτουν τα οικοσυστήματα και την άγρια ζωή».
Πώς να χρησιμοποιούμε τα μαύρα πλαστικά σκεύη με ασφάλεια
Εάν δεν θέλουμε να εγκαταλείψουμε τα μαύρα πλαστικά σκεύη - που εκτός από το ότι είναι στη μόδα είναι και πολύ προσιτά από οικονομική άποψη - υπάρχουν πράγματα που μπορούμε να κάνουμε για να μειώσουμε τον κίνδυνο.
Το πιο εύκολο πράγμα θα ήταν να αποφύγουμε τη χρήση κάθε σκεύους με μαύρο πλαστικό που είναι κατασκευασμένο από ανακυκλωμένο πλαστικό. Δυστυχώς, τα περισσότερα σκεύη δεν φέρουν ετικέτα με τον τύπο του πλαστικού από τον οποίο έχουν παραχθεί.
«Θέλετε να ελαχιστοποιήσετε τις πιθανότητες επιβλαβείς χημικές ουσίες να εκλυθούν από τα πλαστικά στα τρόφιμα», λέει ο δρ Λι. «Αυτό είναι πιο πιθανό να συμβεί κάτω από τρεις κύριες συνθήκες:
#1 Υψηλές θερμοκρασίες, επειδή η θερμότητα κάνει τα μόρια να κινούνται πιο ενεργά, αυξάνοντας τις πιθανότητες μετανάστευσης χημικών ουσιών από το πλαστικό
#2 Μακροχρόνιο μαγείρεμα: Η μεγαλύτερη έκθεση δίνει περισσότερο χρόνο για την έκπλυση των χημικών
#3 Ελαιώδη περιβάλλοντα, καθώς πολλές επιβλαβείς ουσίες είναι λιπόφιλες, που σημαίνει ότι μπορούν να διαλυθούν πιο εύκολα σε λίπη ή έλαια».
Με τι να μαγειρέψουμε αντί για μαύρο πλαστικό
Δεν θέλετε να ρισκάρετε; «Υπάρχουν πολλές εναλλακτικές λύσεις για τα μαύρα πλαστικά μαγειρικά σκεύη», λέει η Χαρλάντερ.
Ξύλο ή μπαμπού: «Είναι φυσικά, μη τοξικά, βιοδιασπώμενα και κατάλληλα για αντικολλητικά σκεύη», λέει η Χαρλάντερ. Ένα πράγμα πρέπει να θυμάστε, όμως: Το ξύλο είναι πιο πορώδες, επομένως απαιτεί προσεκτικό καθαρισμό για να αποφευχθεί η ανάπτυξη βακτηρίων.
Ανοξείδωτος χάλυβας ποιότητας τροφίμων: Η Χαρλάντερ λέει ότι αυτό το υλικό είναι ανθεκτικό, ανθεκτικό στη θερμότητα και ανακυκλώσιμο. Απλά να ξέρετε ότι τα ανοξείδωτα σκεύη δεν μπορούν να χρησιμοποιηθούν σε αντικολλητικά τηγάνια, καθώς μπορεί να χαράξουν την επιφάνεια και να αφαιρέσουν την προστατευτική επίστρωση.
Σιλικόνη: Η σιλικόνη είναι ανθεκτική στη θερμότητα και ασφαλής για αντικολλητικές επιφάνειες, καθιστώντας αυτό το υλικό μια καλή επιλογή για όσους θέλουν να μαγειρεύουν σε υψηλή θερμοκρασία ή να χρησιμοποιούν αντικολλητικά τηγάνια.
ΠΗΓΗ